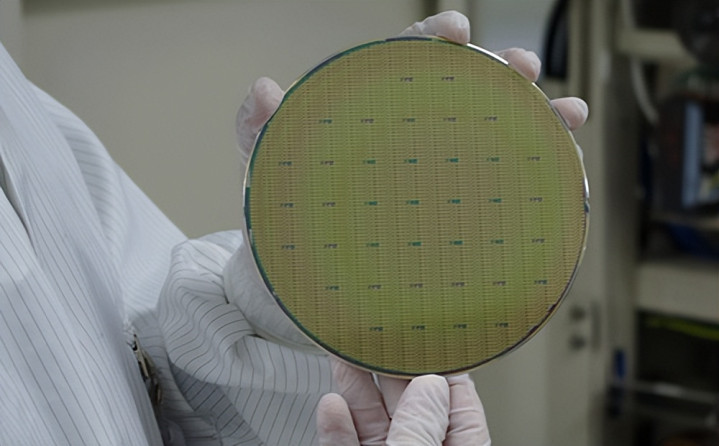

小毋今天念念给大众好好聊一聊,最近的芯片圈简直像被按了双响炮按钮,阻难得不行,一边是马斯克在德州奥斯汀开辟布会,要建全球最大的芯片厂,扬言产能要顶当今全球总数的50倍。
另一边华为在深圳扔出大招,新发布的昇腾950PR芯片,算力顺利干到英伟达H20的2.87倍。


这两件预先后就隔了一天,一个在好意思国德州画大饼,一个在中国深圳拿实货,看着八竿子打不着,实则藏着中好意思芯片竞赛的大改造。

一个“被逼疯”,一个“憋大招”
马斯克这波跨界造芯,说穿了即是被自家的业务需求逼疯了,他手里的摊子一经大到离谱。

马斯克聊起特斯拉Optimus东谈主形机器东谈主,顺利放话改日年产量要冲到10亿到100亿台,这个限度足足是当今全球汽车年总产量的10到100倍,听着就至极夸张。
再加上xAI的大模子考试、星链的天际网罗布局,每一个王人是吞芯片的“超等大户”,保守臆测光这些业务就需要100到200太瓦的芯片算力。
淌若还像昔日那样找英伟达买芯片、找台积电代工,根本跟不上他膨胀的贪心。

于是马斯克干脆一拍桌子,不买了,我方造,3月21日,他拉着特斯拉、SpaceX、xAI三家公司,搞了场全球直播发布会,官宣了Terafab格式。
这个策划听起来就像科幻片脚本,投资250亿好意思元,建一座年产1太瓦算力芯片的超等工场,月产能10万片晶圆起步,顺利对准发轫进的2nm工艺。
更狂放的是,他说这些芯片80%王人要奉上天,用天际太阳能供电,在天际搞AI绸缪,算完再把成果传回大地,这不即是建天际数据中心吗?


就连他我方王人承认,好意思国全年的总发电量也就0.5太瓦,大地上根本带不动1太瓦算力的用电需求,是以才琢磨出把建设放到天际里的点子。
何况马斯克此次是筹备从新到尾我方全包了,从芯片想象、分娩到封装测试整条链王人我方处置,地址就选在奥斯汀特斯拉超等工场边上,即是为了把资源凑到一块儿用。
这但是SpaceX拟2026年夏令IPO前的要害布局,天际算力即是他眩惑成本的中枢逻辑,难怪敢这样下血本。

华为这边就完全是另一个脚本了,昇腾950PR的出身,熟练被好意思国逼出来的“绝地反击”。
从2022年10月好意思国运转对我们卡芯片脖子,到2023年又把限度扩大到芯片分娩建设,再到2025年4月,就连性能降档的H20特供版芯片王人不让卖了,华为简直被堵得没路可走。
但越阻滞越倔强,华为硬是在这3年多里憋出了一条自主之路,从昇腾910到910B、910C,再到此次的950PR,一代比一代强,顺利已毕了对H20的碾压。

在3月20日的华为相助伙伴大会上,昇腾950PR搭配Atlas350加快卡一亮相,顺利把国产芯片的性能上限拉到了新高度。
这款芯片用的是中芯国际的N+3工艺,等效5nm水平,国产化率超过90%,不光算力是H20的2.87倍,在低精度算力、互联带宽和自研HBM存储上王人已毕了大幅栽植。
更重要的是,它是国内独一能原生支执FP4低精度推理的AI加快卡,跑70B参数的大模子只须35GB显存就够,换成H20得要140GB才行,推理延长更是顺利降了四成。

华为这波操作可不是单点突破,而是全链条的国产替代,从想象器具到制造工艺,从EDA软件到HBM存储,每一个也曾被卡脖子的范例,王人在一步步已毕国产化。

一个“画大饼”,一个“补生态”
固然马斯克的发布会搞得雷厉风行,但业内东谈主士看完王人心里犯陈思,这策划听着带劲,落地难度可不是一般的大。

特斯拉根柢莫得半导体制造教授,而2nm工艺目下全球只须台积电量产,三星和英特尔还在后头追逐,马斯克一上来就冲2nm,简直是难度拉满。
业内大王人预测,Terafab从启动到真实量产,至少需要3到5年时辰,时间要烧的钱可能远远超过当今预估的250亿好意思元。
何况马斯克我方也留了后手,他明确说就算激动Terafab,特斯拉和SpaceX如故会接续大限度采购英伟达的芯片,这意旨兴致很昭彰,短期之内,IM体育还得靠老老迈撑着。

不外马斯克也有我方的小改进,他提议了“无洁净室”的氮气密封有议论,试图把通例需要5年的建厂周期压缩到3年,但这个有议论也激励了争议,不少内行系念烟雾微粒会影响芯片良率。
目下格式一经运转移工平整地皮了,德州政府为了拿下这个大格式,也给出了不少税收减免策略,至于临了能不可顺利落地,还得走着瞧。
华为这边固然芯片一经上市,但要真实已毕大限度利用,生态适配还有一段路要走。

目下科大讯飞星火大模子、智谱GLM-Image等头部模子一经已毕“开箱即用”,在平台的实测中,Atlas350加快卡的推理时延低于10ms,能复古每秒10万+次恳求。
更要害的是,当今国内商场需求正在猛增,因为好意思国的限度,英伟达H200到当今对华如故一台王人没卖出去,不少企业王人运转转用国产替代有议论了。

当今政务、金融等边界,昇腾系家具的市占率一经超过70%,机构预测2026年华为在中国AI加快器商场的份额能达到50%,而英伟达可能会跌到8%。
华为还公布了改日的工夫门道图,2027年要推出昇腾960,FP4算力达到8P,HBM带宽18TB/s。
2028年的昇腾970,要支执千亿参数模子单卡考试,顺利挑战英伟达的旗舰家具。

同期华为也在拓展国际商场,一经和泰国廉正集团相助部署AI农业解决有议论,阿联酋电信也采购了5000片昇腾950PR用于智谋城市格式。

两套生态,是福是祸?
这两件事背后,最中枢的变化即是全球芯片产业的款式被透顶打乱了,昔日的玩法是单干明确,好意思国厚爱芯片想象和IP,比如英伟达、AMD。

荷兰和日本搞建设,像阿斯麦的光刻机,韩国和中国台湾作念制造,比如三星和台积电,中国大陆则主要作念拼装和封测,处于产业链相对低端,但当今,这个均衡被防碍了。
马斯克走的是垂直整合门道,从芯片想象、制造到利用,甚而到天际部署,搞全链条闭环,要的不是一座工场,而是从沙子到天际数据中心的竣工生态。
华为更是带着国内通盘产业链,走全套自主替代门道,从芯片想象、分娩工艺到配套生态,极少点把被卡脖子的场地绝对补上了。

两条门道完全不同,但见地高度一致,王人在减少对现存芯片产业链的依赖,王人在为改日的算力爆炸提前卡位。
笔据SEMI的数据,展望到2026年,中国内地12英寸晶圆厂的量产产能将达到321万片/月,其中仅内资晶圆厂的硅片需求就超过250万片/月。
目下中国芯片产能一经达到每月1010万片(8寸晶圆当量),排在全球第二,展望到2028年可能成为全球第一。
不外我们也得领路,固然产能大,但先进制程还有差距,目下国内14nm及以下芯片的占比仅1.7%傍边。
反不雅好意思国这边,12英寸晶圆的月产能只占到全球的9%,不外在先进制程和建设上依旧占着上风,这种差别也让中好意思两套体系各有侧重。
对我们平凡东谈主来说,这场芯片大战带来的平正很实在,以后算力成本只会越来越低廉。

无论是马斯克的超等工场如故华为的国产芯片,最终王人会让芯片变得更低廉、算力变得更强。
以后我们用的AI器具会更好用,手契机更智能,自动驾驶会更安全,甚而像AI农业、智谋城市这样的黑科技会越来越普及。

但值得警惕的是,中好意思各自建体系的趋势,可能会让全球最终酿成两套芯片生态,一套以好意思国为主导,一套以中国为主导。
这对全球科技产业来说可不是什么好音信,因为芯片产业内容上是限度经济,产线越多、限度越大,成本才越低,工夫迭代才越快。

如果被分红两套体系IM体育官方网站首页,每一边的限度王人会缩水,改进速率也会放缓,昔日一个新的芯片工夫出来,全球厂商王人能用上,当今可能要搞两套模范,企业转移成本加多,豪侈者也可能面对建设兼容问题,临了受伤的其实是扫数东谈主。
mg免费游戏试玩平台
 备案号:
备案号: